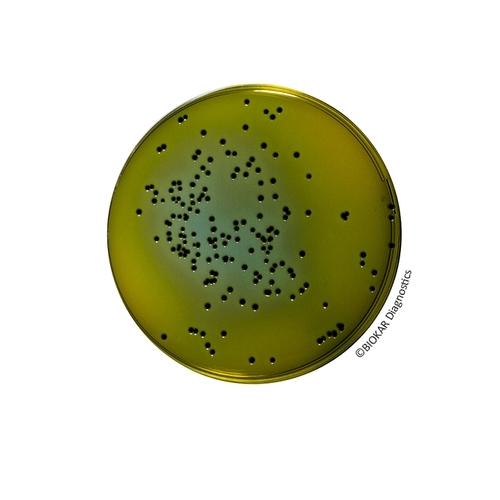
Hektoen Enteric Agar

Hektoen Enteric Agar
Hektoen Enteric Agar is a selective medium for the isolation and differentiation of pathogenic enterobacteria from biological samples of animal origin, water samples, dairy products and other food products. It is used in animal health in the context of Salmonella detection in mammals. The medium is also recommended for the detection of Shigella, in food microbiology. Hektoen Enteric agar can also be used as the second media of choice in the standardized methods for the detection of Salmonella.